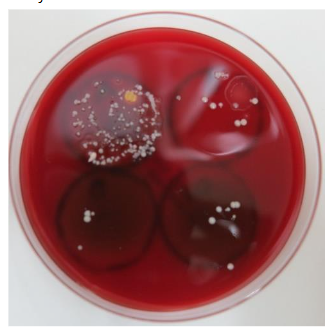
Figure 2. Offensive disinfection activity of tobacco and incense stick smoke. Stamp cultures of test plates on agar medium; ten vocalizations (“Ba, Bi, Bu, Be, Bo, Pa, Pi, Pu, Pe, and Po”) onto sterilized plastic plates placed 20~30cm from the mouth resulted in the formation of approximately 150CFU of bacteria and fungi. Biomass smoke from tobacco and incense sticks suppressed colony formation to a similar extent as electrolyzed saline.
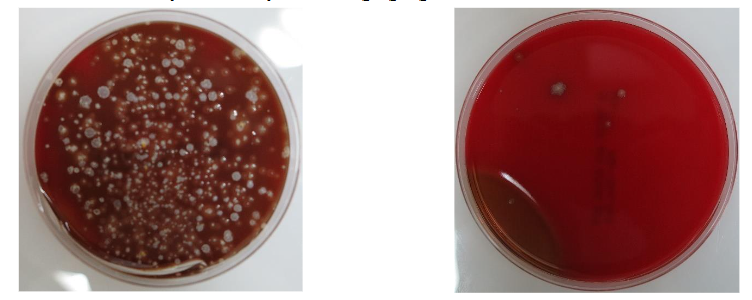
This image has an empty alt attribute; its file name is image-28.png

Impact of Biomass Smoke on Pneumonia Morbidity in Japan
Effects of A Small Dose of Biomass Smoke on The Morbidity of Community-acquired Pneumonia; A Multivariate Regression Analysis of 1600 Patients
Kembu Nakamoto1, MD, PhD, Sadahiro Kawamoto1, MD, PhD
- Division of General Thoracic Surgery and Division of Respiratory Medicine, Shunan Memorial Hospital, Kudamatsu, 744-0033 Japan
Email: [email protected]
OPEN ACCESS
PUBLISHED 30 September 2025
CITATION Nakamoto, K., Kawamoto, S., 2025. Effects of A Small Dose of Biomass Smoke on The Morbidity of Community-acquired Pneumonia; A Multivariate Regression Analysis of 1600 Patients. Medical Research Archives, [online] 13(9). https://doi.org/10.18103/mra.v13i9.6908
COPYRIGHT: © 2025 European Society of Medicine. This is an open-access article distributed under the terms of the Creative Commons Attribution License, which permits unrestricted use, distribution, and reproduction in any medium, provided the original author and source are credited.
DOI https://doi.org/10.18103/mra.v13i9.6908
ISSN 2375-1924
ABSTRACT
The annual number of deaths from pneumonia has markedly increased with the decrease in the prevalence of smoking since the 1980s in Japan. A small dose of biomass smoke functions as a disinfectant against droplet-borne biologic microbes, and smokeless residence has been proposed as one cause of the high incidence of pneumonia. The present study retrospectively investigated the effects of biomass smoke on the morbidity of pneumonia using a multivariate regression analysis. This study analyzed 1600 patients with pneumonia or parapneumonic pleuritis between 2010 to 2021. A total of 181 health examinees for chest CT screening in 2019 were used as the control group. The following variables were selected for the analysis; sex, age, the smoking status, nursing care status, comorbidities, disease history, vaccination status, season, residence smoking status, pathogens, disease severity, medical interventions, and disease prognosis. The primary outcome was the morbidity of pneumonia, and the secondary outcomes were disease prognosis and the detection of pathogens. Most pathogens were resident flora of droplet-borne contamination. A smokeless environment significantly increased the detection rate of pathogens associated with sever disease and a poor outcome. Patients with a low performance status had a significantly worse outcome. Indoor seasons and smokeless environments significantly increased morbidity, while vaccination and current smoking markedly reduced morbidity. The main cause of pneumonia was speculated to be droplet-borne infection in smokeless community spaces. Smokeless residences appear to have increased the morbidity of pneumonia.
Keywords
- biomass smoke
- community-acquired pneumonia
- morbidity
- multivariate regression analysis
Introduction
The number of annual deaths from community-acquired pneumonia has markedly increased by 4-to 5-fold from the pre-1980s level of approximately 30,000 deaths in Japan, despite improvement in residential hygiene and a decrease in the prevalence of smoking. Annual mortality is similar to that during Spain flu pandemics. We previously suggested that the risk of pneumonia was higher in a smokeless indoor communal environment than in an environment where smoking is permitted. A low dose of biomass smoke, cigarette or incense smoke, functions as a disinfectant against droplets and air-borne pathogens, and facilitates the gulfing of tar-labelled microbes as carbonic foreign particles by macrophages. Among current hygiene procedures, only biomass smoke disinfects room air contamination. Therefore, the present study retrospectively investigated the effects of biomass smoke on the morbidity of community-acquired pneumonia using a multivariate regression analysis.
Patients and Methods
The Institutional Review Board of our hospital granted ethical approval for this study (IRB approval #02-02, SMH, Nov. 11, 2020). Informed consent was obtained from each patient. In this retrospective study, data were acquired from attending physicians and/or electronic medical records or through telephone inquiries or patient interview. Patients with acute pneumonia, including parapneumonic pleuritis with effusion or empyema and excluding aspiration pneumonia with the clinical feature of dysphagia or food in the large airways on CT images, who were admitted to Shunan Memorial Hospital between January 1, 2010 to December 31, 2021, which corresponded to the end of the δ-variant COVID-19 pandemic and before smokeless cigarette era, were analyzed. Patients of readmission for recurrent pneumonias were excluded. Acute pneumonia was diagnosed by chest CT, clinical features, a hematological examination, a bacterial culture of sputum or effusion, and/or specific PCR examinations or immunological test for biological microbes. Health examinees who visited our hospital for lung cancer screening by chest CT between January 1 and December 31, 2019 were used as the control group because the majority were annual repeaters. A multivariate analysis of different categories of variables was performed. Host variables were as follows: sex, age, the current smoking status, performants status, Charlson’s comorbidity score, respiratory comorbidities, such as COPD, chronic infections, immune diseases, and malignancies, nursing care services, and vaccination for pneumococcal pneumonia. Close conversations spreads millions of droplets-borne microbes in a short time, while contact or air-borne contamination contains a small number of microbes. The elderly and individuals receiving nursing care services are routinely exposed to droplet-borne biocontamination due to the need for close conversations as a result of hearing impairments and contact nursing care. Individuals aged 75 years or older, those with hearing impairments, and those receiving nursing care services were defined as a high-risk group of droplets-born infections, while individuals younger than 75 years and not receiving nursing care services were defined as a low-risk group. The environmental variables included in the multivariate analysis were as follows: indoor seasons (December to March, July and August, representing cold, hot, and rainy periods, respectively); outdoor seasons (April to June, October and November); residence style (single or group living); residence type; and indoor smoking status (smoking allowed or smokeless). Based on the prevalence of smoking in the control group, approximately 70% of individual homes were presumed to have no smoking restrictions. In addition, about 30% of Japanese households are Buddhists who burn incense sticks twice daily. Consequently, approximately 80% of individual homes were speculated to have a smoke-exposed indoor environment. Welfare facilities and residences occupied by a single non-smoker or a couple with at least the male partner as a non-smoker were defined as having “smoking restrictions.” Other individual homes were defined as “smoking allowance.” The detection of pathogens, epidemic or resident flora, and drug resistance were selected as pathogen site variables. The positive detection of pathogens indicated exposed to a high pathogen load and negative detection as that to a low load. Disease severity (lesions on CT images and CRP levels) and the disease category of pneumonia or parapneumonic pleuritis were selected as disease site variables. Interventions with nasal or pleural space irrigation using electrolyzed saline, and respiratory rehabilitation, used as optional to conventional treatment, were selected as intervention variables. In-hospital prognosis was selected as the outcome variable of pneumonia. Explanatory variables with a small regression coefficient in the same category in the initial analysis were deleted from the final analysis for compact tables. The control group was used in the analysis of the morbidity of pneumonia.
Statistical analysis
A multivariate regression analysis was used in the present study. Analyses were performed using Excel statistical software (Excel statistics 2020; Ekuseru-Toukei 2020, Social Survey Research Information Co. Ltd, Tokyo). The regression coefficients of the explanatory variables were interpreted as indicators of risk of the outcomes, including pneumonia morbidity. A regression coefficient with a p-value <0.05 was considered to be significant.
Results
A total of 1600 patients were admitted to Shunan Memorial Hospital under a diagnosis of acute pneumonia and 181 health examinees visited our hospital for lung cancer screening by chest CT.
Subjects’ profiles (Table 1):
| Variables | Pneumonia group; n=1600 (Jan 2010-Desc 2021) | Control group; n=181 (Jan-Desc 2019) |
|---|---|---|
| Host Sex; male/female | 938/661 | 108/73 |
| Age; ≦75years / >75years | 552/1048 | 150/31 |
| Smoking status; non-smoker/current smoker | 1502/98 | 122/59 |
| Brinkman index (cigarettes/day× smoking year); 0/≦1000/>1000 | 1256/229/115 | 92/65/24 |
| Performance status; 0/1/2/3/4 | 747/258/138/457 | 177/4/0/0 |
| Nursing care service; no/yes | 756/844 | 171/10 |
| Charlson’s comorbidity score; free or mild/moderate or severe | 1004/596 | 168/13 |
| Comorbid respiratory disease; no/yes | 1000/600 | 153/28 |
| Droplet-borne infection; low- /high-risk group | 446/1154 | 149/32 |
| Previous history of pneumonia; no/yes | 1230/370 | 175/6 |
| Pneumococcal vaccination; finished/not yet | 82/1518 | 53/128 |
| Environment Season; indoor/outdoor | 1022/578 | 80/101 |
| Residence style; single/group | 232/1368 | 28/153 |
| Residence; welfare facility/individual home | 287/1313 | 4/177 |
| Smokeless residence/smoke allowed residence | 811/789 | 35/146 |
| Pathogen Detection; negative / unknown / positive | 346/524/730 | |
| virus/bacteria/fungus / not detected nor examined | 104/603/23/870 | |
| epidemic/unknown/resident flora | 121/582 /897 | |
| resistant/unknown/sensitive to drugs | 271/ 638/691 | |
| Disease Affected lesions; single lobe or less / multiple lobes | 743/857 | |
| Pneumonia / parapneumonic pleuritis | 1425/175 | |
| Prognosis Hospitalized stay; ≦2wk/>2wk/death after2wk/death within2wk | 672/701/125/102 | |
| Discharged/hospital death | 1373/227 | |
| Intervention Respiratory rehabilitation; no/yes/unknown | 910/376 /314 | |
| Electrolyzed saline irrigation; no/yes | 1510/90 |
Host site profile variables were as followed. In the patient group, approximately 67% of individuals were older than 75 years, whereas in the control group, approximately 83% were younger than 75 years. The sex ratio was similar between the two groups. The majority of females were housewives who had few opportunities to visit or stay in community places. The current smoker ratio was smaller in the patient group than in the control group. The prevalence of smoking in the control group was similar to that in the Japan Tobacco (JT) annual report. The patient group had a poorer performance status, a higher Charlson’s comorbidity score, and more frequently had comorbid respiratory diseases than the control group. The patient group also included a higher percentage of individuals at an increased risk for droplet-borne infections than the control group. Among pneumonia patients, 375 (23.1%) had a previous history of pneumonia. Furthermore, only 82 of 1,601 patients (5.4%) had completed pneumococcal vaccination upon admission, in contrast to 53 of 181 examinees (29.3%) in the control group. Environmental site profiles were as follows: approximately two-thirds of patients were admitted during indoor seasons, when more time is typically spent in air-conditioned communal spaces. Around 20% of patients were admitted from welfare facilities. Half of the residences had indoor smoking restrictions. Disease site profiles were as follows. Pneumonia lesions were in a single lobe or less in approximately half of patients, and in multiple pulmonary lobes in the remaining patients. CRP levels on hospital admission ranged 0.5 to 47 mg/dl (normal range: between 0.05 and 0.30 mg/dl). Among pneumonia patients, 501 (31.7%) received respiratory rehabilitation during their hospital stay. Eighty-three patients with parapneumonic empyema and COVID19 pneumonia received an intervention with electrolyzed saline irrigation of the intrapleural or naso-oral cavity. In total, 1372 patients discharged to their homes or transferred to other welfare facilities, while remaining 226 died in the hospital; therefore, the hospital mortality rate of pneumonia was 14.1%. Overall, 680 patients were discharged within 2 weeks and 694 after 2 weeks. A total of 124 patients died after a 2-week hospital stay, while 109 patients had an early hospital death within 2 weeks.
Pathogens (Table 2):
| detected/not detected/not examined | 745/346/524 |
|---|---|
| Viral pneumonia | 104 |
| Bacterial pneumonia | 738 |
| Fungal pneumonia | 23 |
| Influenza virus | 62 |
| Streptococcus Pneumoniae | 234(30) |
| Aspergilluus | 4 |
| δ variant COVID19 | 28 |
| Haemophilus Influenzae | 112(3) |
| Candida | 16 |
| Cytomegalovirus | 13 |
| MRSA | 78 |
| Pneumocystis carinii | 3 |
| Epstein Barr (EB) | 1 |
| Staphylococci | 47(8) |
| Klebsiella pneumoniae | 38(3) |
| Branhamella catarrhalis | 36(1) |
| Streptococci | 10 |
| Pseudomonas | 32 |
| Haemophilus influenza | 4 |
| E. coli | 32(7) |
| Branham cat | 3 |
| Mycoplasma | 27 |
| Pseud | 3 |
| Corynebacterium | 17(13) |
In total, 865 pathogens were detected in 745 patients, but not in 346. Microbiological examinations were not performed on 524 patients because symptoms were mild or difficulties were associated with sputum sampling. The primary pathogens were viral in 104 patients, bacteria in 695, and fungal in 23. The following epidemic pathogens were detected: Influenza virus in 62 patients, δ variant COVID19 in 28, and Mycoplasma in 27. Other pathogens were resident flora of air or droplet-borne contamination. The most frequently detected viral pathogen was Influenza virus, followed by bacterial pneumonia in 25 patients and Cytomegalovirus pneumonia in 13 patients. Rare pathogens of Epstein-Barr virus, Pneumocystis pneumoniae and Legionella were detected in 5 patients. The most frequently detected pathogens were bacteria. Streptococcus pneumoniae, Hemophilus influenza and methicillin-resistant Staphylococcus aureus (MRSA) were the main pathogens of bacterial pneumonia, followed by Staphylococci, Klebsiella pneumoniae, Branhamella catarrhalis, Pseudomonas, and Escherichia coli. All pathogens of empyema were pyogenic bacteria of the resident flora. Among bacterial pathogens, 190 exhibited drug resistance (27%) against more than 3 antibiotics.
Table 3. Multivariate regression analysis of the detection of pathogens
Objective variable; Detection of pathogens: negative (346) / unknown (524) / positive (730)
| Variables | regression coefficient | lower limit | upper limit | P value |
|---|---|---|---|---|
| Host site Sex; female / male | 0.0206 | -0.0595 | 0.1007 | 0.6143 |
| Age; ≦75years / >75years | -0.0261 | -0.1667 | 0.1145 | 0.7156 |
| Current smoker / non-smoker | -0.1002 | -0.2660 | 0.0656 | 0.2361 |
| Brinkman Index; 0 / ≦1000 / >1000 | -0.0133 | -0.0292 | 0.0025 | 0.0995 |
| Nursing care service; yes / no | -0.0677 | -0.1761 | 0.0406 | 0.2203 |
| Charlson’s score; free, mild / moderate, sever | 0.0786 | -0.0095 | 0.1667 | 0.0802 |
| Comorbid respiratory disease; no / yes | -0.0208 | -0.1021 | 0.0605 | 0.6157 |
| Droplet borne infection; low risk / high risk | 0.0829 | -0.0884 | 0.2542 | 0.3428 |
| Previous history of pneumonia; no / yes | 0.0818 | -0.0084 | 0.1720 | 0.0754 |
| Pneumococcal vaccine; not yet / finished | -0.1635 | -0.3306 | 0.0035 | 0.0550 |
| Environment Season; outdoor / indoor | -0.0760 | -0.1522 | 0.0001 | 0.0504 |
| Residence; welfare facility / individual home | 0.0172 | -0.0113 | 0.0457 | 0.2373 |
| Smokeless environment / smoke allowed environment | 0.1476 | 0.0607 | 0.2344 | P < 0.001** |
| Disease Affected region; single lobe or less / multiple lobes | 0.0823 | 0.0077 | 0.1569 | 0.0306* |
| CRP 0.5~1.0 / 1.0~20 /> 20~ | 0.0322 | -0.0280 | 0.0924 | 0.2940 |
| Disease category; Pneumonia / parapneumonic empyema | -0.1637 | -0.2979 | -0.0296 | 0.0168* |
| Prognosis Hospital stay; ≦2wks / >2wks / hospital death after 2wks / hospital death within 2wks | 0.0537 | 0.0040 | 0.1034 | 0.0341* |
*; P<0.05, **; P<0.01, (n); number of patients
Patients from environments where smoking is permitted had a significantly lower detection rate of pathogens (p<0.001). This result suggests that biomass smoke may routinely suppress both epidemic and resident environmental pathogens. The affected lung regions were significantly smaller in patients with negative pathogen detection (p<0.05). In contrast, empyema was associated with a significantly higher rate of pathogen detection and a poorer prognosis. These results indicate that exposure to a high pathogen load is associated with more severe disease and worse outcomes. Therefore, airborne or droplet-transmitted pathogenic microbes appeared to be suppressed in environments where smoking is permitted.
Table 4. Multivariate regression analysis of outcome of pneumonia
Prognosis; hospital stay <2wks / >2wks / Hospital death after 2wks / Hospital death before 2wks: 672/701/125/102
| Variables | regression coefficient | lower limits | upper limits | P value |
|---|---|---|---|---|
| Host Sex; female / male | -0.1032 | -0.1820 | -0.0243 | 0.0104* |
| Age; ≦75years / >75years | -0.2306 | -0.3662 | -0.0951 | P<0.001** |
| Current smoker / non-smoker | -0.0140 | -0.1775 | 0.1495 | 0.8666 |
| Brinkman Index; 0 / ≦1000 / >1000 | 0.0150 | -0.0007 | 0.0306 | 0.0604 |
| Nursing care service; no / yes | -0.2883 | -0.3935 | -0.1832 | P<0.001** |
| Charlson’s score; free, mild / moderate, sever | 0.2857 | 0.1999 | 0.3715 | P<0.001** |
| Comorbid respiratory disease; no / yes | -0.0718 | -0.1520 | 0.0085 | 0.0795 |
| Droplet-borne infection; low risk / high risk | -0.0159 | -0.1815 | 0.1497 | 0.8508 |
| Previous history of pneumonia; no / yes | -0.1244 | -0.2133 | -0.0355 | 0.0061** |
| Pneumococcal vaccine; not yet / finished | 0.0118 | -0.1535 | 0.1771 | 0.8889 |
| Environment Season; outdoor / indoor | 0.0125 | -0.0628 | 0.0879 | 0.7444 |
| Residence; welfare facility / Individual homes | 0.0553 | 0.0273 | 0.0833 | P<0.001** |
| Smoke allowed environment / smokeless environment | -0.0034 | -0.0891 | 0.0823 | 0.9383 |
| Pathogen Detection; negative / unknown / positive | 0.0151 | -0.0358 | 0.0660 | 0.5606 |
| Epidemic / unknown / resident flora | -0.1152 | -0.1747 | -0.0556 | P<0.001** |
| Drug resistant / unknown / drug sensitive | 0.1419 | 0.0898 | 0.1940 | P<0.001** |
| Disease Affected region; multiple lobes / single lobe or less | 0.1727 | 0.1001 | 0.2453 | P<0.001** |
| Parapneumonic pleuritis / pneumonia | 0.2522 | 0.1214 | 0.3830 | P<0.001** |
| Intervention Respiratory rehabilitation; yes / no | 0.0300 | -0.0168 | 0.0769 | 0.2088 |
| Electrolyzed saline irrigation; yes / no | -0.2121 | -0.3957 | -0.0286 | 0.0235* |
*; P<0.05, **; P<0.01, n; number of patients
Pneumonia is a serious disease with a mortality rate of 14%. Most pathogens were resident flora of air or droplet-borne contamination. Drug-resistant pathogens were associated with significantly poor outcomes. Males, an advanced age, patients with a poor performance status and comorbidities, recurrent pneumonia, and residents of welfare facilities had significantly poor outcomes. Severe pneumonia and empyema were associated with a significantly poor outcome. Of the clinical interventions analyzed, electrolyzed saline irrigation for empyema and viral pneumonia, particularly δ variant COVID19 pneumonia, rapidly improved disease outcomes. The low contribution of variable for pathogen detection on the poor disease outcome may have been masked by the effects of electrolyzed saline, which was used only for the positive detection of pathogens.
Table 5. Multivariate regression analysis of the morbidity of pneumonia
Objective variable: pneumonia group (1600) / control group (181)
| Variable | regression coefficient | lower limits | upper limits | P value |
|---|---|---|---|---|
| Host Sex; female / male | -0.0145 | -0.0416 | 0.0126 | 0.2948 |
| Age; ≦75years / >75years | 0.0054 | -0.0423 | 0.0532 | 0.8242 |
| Current smoker / non-smoker | -0.1582 | -0.2074 | -0.1091 | P<0.001** |
| Brinkman Index; 0 / ≦ 1000 / 1000 | 0.0001 | -0.0056 | 0.0057 | 0.9763 |
| Nursing care service; no / yes | -0.0331 | -0.0695 | 0.0033 | 0.0749 |
| Charlson’s score; free, mild / moderate, sever | 0.0193 | -0.0109 | 0.0494 | 0.2100 |
| Comorbid respiratory disease; no / yes | -0.0287 | -0.0566 | -0.0008 | 0.0439* |
| Droplet-borne infection; low risk / high risk | -0.1294 | -0.1866 | -0.0722 | P<0.001** |
| Previous history of pneumonia; yes / no | 0.0571 | 0.0255 | 0.0887 | P<0.001** |
| Pneumococcal vaccine; not yet / finished | 0.2750 | 0.2291 | 0.3209 | P<0.001** |
| Environment Season; outdoor / indoor | -0.0697 | -0.0951 | -0.0443 | P<0.001** |
| Welfare facility / individual homes | 0.0002 | -0.0097 | 0.0102 | 0.9615 |
| Smoke allowed environment / smokeless environment | -0.0305 | -0.0604 | -0.0006 | 0.0455* |
*: P<0.05 **: P<0.01, (n); number of patients or examinees
A multivariate regression analysis was used to investigate the effects of host and environmental site variables on the morbidity of pneumonia, including the control group. Vaccination resulted in the most significant decrease in the morbidity of pneumonia, followed by current smoking. The high-risk group for droplet-borne infections, individuals with a previous history of pneumonia, indoor seasons, and smokeless environments significantly increased the morbidity of pneumonia. Recurrent pneumonia may be attributed to continuous residence in a smokeless environment. High-risk factors for comorbid respiratory diseases may be chronic infection with Pseudomonas or MRSA in patients with bronchiectasis. Sex, age, and poor performance status were not associated with the morbidity of community-acquired pneumonia. Collectively, these results suggest that routine exposure to indoor smoke may reduce the morbidity of community-acquired pneumonia. In the present study, no adverse effects of so-called “passive smoking” on pneumonia or comorbid respiratory diseases were observed, even though more than 95% of non-smokers in Japan are estimated to have been exposed to passive smoke from their parents or partners.
Discussion
The number of annual deaths from community-acquired pneumonia has markedly increased by 4-to 5-fold from the pre-1980s level of approximately 30,000 deaths in Japan, despite improvement in residential hygiene and a decrease in the prevalence of smoking. Annual mortality is similar to that during Spain flu pandemics.

We previously suggested that the risk of pneumonia was higher in a smokeless indoor communal environment than in an environment where smoking is permitted. A low dose of biomass smoke functions as a disinfectant against droplets and air-borne pathogens.

Biomass smoke has been shown to facilitate the engulfing of tar-labeled microbes, even novel viruses, as foreign particles by macrophages.

Among current hygiene procedures, only biomass smoke disinfects room air contamination. The adverse effects of passive smoking are negligible, because quite small dose of smoke particle, diluted with air, is inhaled by passive smoking.

Pneumonia is a serious disease, and its mortality rate was higher than that of COVID-19, reported in a mid-sized facility comparable our hospital. A multivariate analysis of pathogens suggested that disease severity and outcomes depended on the pathogen load. The number of biological microbes was previously shown to be higher in vocalized droplets than in air; therefore, the main cause of pneumonia was speculated to be droplet-borne infections. Among the host site variables examined in the present study, advanced age, serious comorbidities, and the use of nursing care services were the strongest risk factors for poor outcomes of pneumonia, followed by the presence of empyema, severe pneumonia, recurrent pneumonia, and drug-resistant pathogens. An intervention using electrolyzed saline was previously shown to significantly improve disease outcomes. Electrolyzed saline is a novel disinfectant with broad-spectrum activity against viruses, bacteria, and fungi. It is currently considered a highly effective and versatile disinfectant that is non-toxic and easy to use. It may serve as a first-line barrier in future novel pandemics, but is currently available in Japan only.
Figure 6. Disinfection activity of electrolyzed saline gargling.
Vaccination and current smoking resulted in the greatest reductions in the rate of pneumonia. The outdoor season and environments where smoking is permitted may reduce both exposure to a high pathogen load and disease severity. An environment where smoking is permitted generally suppressed both epidemic and resident flora pathogens. Disease morbidity was significantly increased in the high-risk group for droplet-borne infections. Therefore, vaccination is strongly recommended for these patients. Disease morbidity was not dependent on the host-related variables of sex, age, and a poor performance status. Morbidity was mainly dependent on the resident environment. The present results showed that the main cause of community-acquired pneumonia was droplet-borne infections in indoor communal spaces with smoking restrictions. The results of the multivariate analysis support our hypothesis.
Biomass smoke has served as an incidental environmental disinfectant since humans began using biomass fuels for daily living¹⁶. The low incidence of COVID19 infections in refugee camps where biomass fuel was burned on the ground, one-seventh that in the general population, provide support for the function of biomass smoke¹⁷. Biomass smoke exhibits both offensive and defensive antimicrobial activities against droplet-borne microbes⁵. (Figure 2, 3) Smoke particles kill microbes that adhere to the surface of the upper airway mucosa and may also intercept inhaled pathogens by attaching to the mucosal surface. Smoke tar has lipid affinity to the surface of microbes, which are covered with a lipid cell wall or envelope. Smoke particles are also charged with static electricity and can readily capture negatively charged microbes.
Biomass smoke was eliminated from indoor spaces when biomass fuel was replaced with smokeless natural gas or electricity in the 1970s. Tobacco and incense smoke may represent the last remaining line of defense against biological contamination of indoor air in the absence of other alternatives. The hygiene level of environments where smoking is permitted is similar to that of semi-clean rooms³. The complete elimination of biomass smoke from community spaces has been suggested to increase the risk of transmission of pneumonia. Pure oxygen is toxic to biological tissues, whereas air, which comprises diluted oxygen and nitrogen gas, is essential for biological tissues. According to the same logic proposed by the toxicologist Paracelsus¹⁸, a large amount of biomass smoke acts as an irritant to biological tissues; however, small doses may be essential for hygiene management in indoor communal spaces. Incidentally, the first outbreak of COVID19 in Japan was detected at the same time as legal smoking restrictions were initiated for indoor communal spaces on April 1, 2020²⁰. The elimination of tobacco smoke from indoor communal spaces may decrease the security of public health and contribute to future novel pandemics.
Conclusions
The main cause of pneumonia is droplet-borne infections, which are suppressed in an environment where smoking permitted. The elimination of biomass smoke from indoor communal spaces may increase the morbidity of community-acquired pneumonia.
Conflict of Interest Statement:
None.
Funding Statement:
None.
Acknowledgements:
We appreciate Dr Kazuo Neriishi for his advice on statistical analyses and Mrs. Yoko Ishikawa for data administration.
Disclosure statement;
The authors have no conflicts of interest relating to this study.
References:
- JT annual report 2018. www.health-net.or.jp/tobacco/product/pd100000.html
- Ikeda K, Ishikawa T. Historical overview of pneumonia deaths in Japan. Ann Rep Tokyo Metr Inst Pub Health. 2018; 69: 271-277.
- Nakamoto K, Kawamoto S, Kawamura Y, et al. Background analysis of community acquired pneumonia: Environmental biocontamination in residential spaces. Scivis Microbiol Infect Dis. 2021; 5: 1-6.
- Kuhn III D. The cells of the lung and their organelles. In Crystal RG. Ed. The biochemical basis of pulmonary function. 1976; 30. Marcel Dekker, New York, Basel.
- Nakamoto k, Maeda M, Taniguchi K, et al. A study on optimal temperature for isolated lung preservation. Ann Thorac Surg. 1992; 53: 101-108.
- Charlson ME, Pompei P, Ales KL, MacKenzie CR. A new method of classifying prognostic comorbidity in longitudinal studies: Development and validation. J Chronic Dis 1987; 40:373-83.
- Japanese Agency for Cultural Affairs. Religion Annual Report. 2019. https://www.bunka.go.jp accessed; Jan 20,2021.
- Yamamura O, Onishi H, Sakamaki I, et al. Infection rate among close contacts of patients with coronavirus disease in Japan: a descriptive study and literature review. Asian Biomed 2023; 17:115-23.
- Neriishi K, Nakashima E, Delongchamp RR. Persistent subclinical inflammation among A-bomb survivors. Int J Radiat Biol. 2001; 77:475-82.
- Hirayama T. Non-smoking wives of heavy smokers have a high risk of lung cancer: a study from Japan. Br Med J. 1981; 282: 183-185.
- Nakamoto K Perspectives: Smoking regulation in indoor communal spaces and COVID-19 outbreaks. Scivis Microbiol Infect Dis. 2022;6(2):1-2.
- Miki Y, Kido T, Taniguchi K, et al. Analysis for morbidity and outcomes of COVID19. J Osaka Univ Sofukai 2021; 10: supl 239.
- Nakamoto K, Takeshige M, Fujii T, et al. Electrolyzed saline for elimination of bacterial colonization in the empyema space. Surg Infect. 2016; 17: 724-729.
- Nakamoto K, Hashiyada H, Kawamoto S, et al. First aid disinfection by gargling electrolyzed saline for COVID-19 infections. Scivis Microbiol Infect Dis. 2022; 6: 1-7.
- Rutala WA, Weber DJ, and the health care infection control practices advisory committee. Guide line for disinfection and sterilization in healthcare facilities, 2008. Accessible version: https//www.cdc.gov/infectioncontrol/guidelines/disinfection.
- Parmeter Jr JR, Uhrenhold B. Effects of smoke on pathogens and other fungi. Proceeding, #14 Tall Timbers Fire Ecology Conference. 1976; 299-304.
- Asahi shinbun comp. COVID19 infection in refugee camp. 2021; Jan 21. https://www.asahi.com/articles accessed on June14,2025.
- Mori C. The electric charges of incense-stick smoke and candle frame. Aichi Tech Univ Research Report. 2013; 50: 198-119.
- Wikipedia. Paracelsus www.en.wikipedia.org/wiki/Paracelsus: accessed May 26, 2025.
- NHK. Report of COVID19; https://www3.nhk.or.jp/news/special/coronavirus/data-all/ accessed on June 11. 2025.

